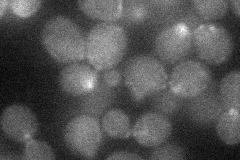
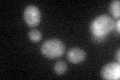

View description
Protein involved in bud-site selection; diploid mutants display a unipolar budding pattern instead of the wild-type bipolar pattern, and bud at the distal pole
Localization:
Intensity:
Fold change:
Significance:
-
C’ GFP library in SD

bud neckN/A -
N' NOP1pr-GFP in SD
bud neck22.805 -
N' TEF2pr-mCherry in SD

cell periphery,vacuole11.5143 -
N' NATIVEpr-GFP in SD

below threshold16.8967 -
N' TEF2pr-VC and Cyto-VN in SD

below threshold24.0861 -
C’ GFP library in SD+DTT
bud neck17.081.08No -
C’ GFP library in SD+H2O2

bud neck17.811.12No -
C’ GFP library in Starvation Media

bud neck18.451.16No -
C’ GFP library on the background of Pup2-DaMP

bud neck -
C’ GFP library on the background of CCT mutant

bud neck17.16741.08712No
